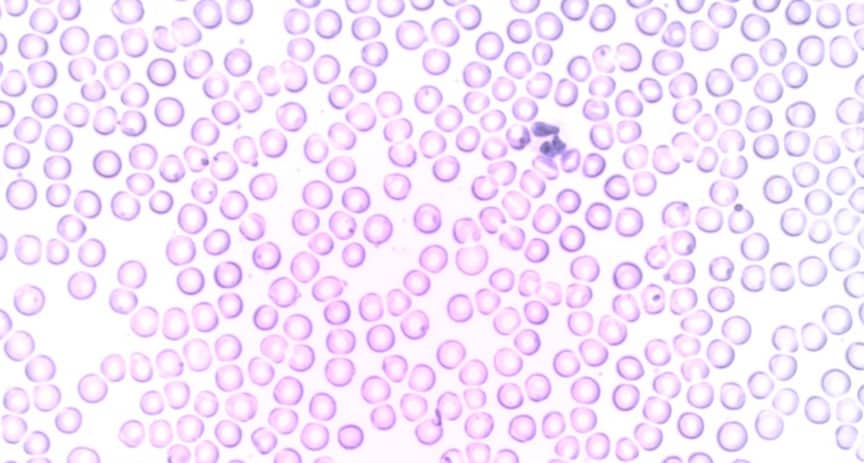

Sebelum ini telah ditulis mengenai CML yang fokus pada terapi pada kasus fase kronik CML. Pada artikel tersebut dijelaskan bahwa terdapat 3 fase CML yaitu fase kronik, akselerasi, dan krisis blas. Dalam kesempatan ini akan dibahas tentang CML fase akselerasi dan CML krisis blas. Cecep Suryani Sobur Seorang dokter, saat ini sedang menjalani pendidikan dokter spesialis penyakit dalam FKUI. Peminat …
Leukemia Granulositik Kronik (LGK) atau Chronic Myelogenous Leukemia (CML)
Leukemia granulositik kronik (LGK) atau dalam bahasa Inggris chronic myelogenous leukemia (CML) merupakan gangguan sel punca klonal yang masuk dalam golongan myeloproliferative neoplasms (MPN). Berbeda dengan leukemia akut, CML memiliki perjalanan penyakit yang lebih panjang, gejala yang muncul bertahap lebih lama, dan bisa dikatakan “lebih jinak”. Bahkan, saat ini dengan pengobatan target yaitu melalui obat-obatan inhibitor tirosin kinase, CML saat …
Diagnosis dan Tatalaksana Polycythemia Vera (PV)
Polycythemia vera (PV) adalah suatu keadaan atau penyakit dimana terjadi produksi sel darah merah yang berlebihan. PV adalah bagian dari kelompok penyakit yang dinamakan myeloproliferative neoplasm (MPN). MPN dapat dibagi menjadi beberapa kelompok lagi, yaitu: Cecep Suryani Sobur Seorang dokter, saat ini sedang menjalani pendidikan dokter spesialis penyakit dalam FKUI. Peminat berbagai topik sejarah dan astronomi. caiherang.com